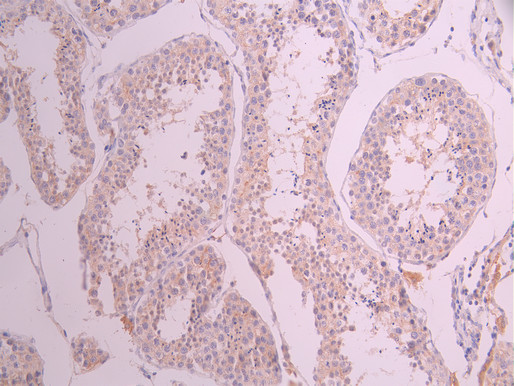

ARG1 Recombinant Monoclonal Antibody
-
中文名稱:ARG1 Recombinant Monoclonal Antibody
-
貨號:CSB-RA002005MA1HU
-
規格:¥1320
-
圖片:
-
IHC image of CSB-RA002005MA1HU diluted at 1:50 and staining in paraffin-embedded human liver tissue performed on a Leica BondTM system. After dewaxing and hydration, antigen retrieval was mediated by high pressure in a citrate buffer (pH 6.0). Section was blocked with 10% normal goat serum 30min at RT. Then primary antibody (1% BSA) was incubated at 4°C overnight. The primary is detected by a Anti-Human lgG, Fcy Fragment Specific labeled by HRP and visualized using 0.05% DAB.
-
IHC image of CSB-RA002005MA1HU diluted at 1:50 and staining in paraffin-embedded human liver cancer performed on a Leica BondTM system. After dewaxing and hydration, antigen retrieval was mediated by high pressure in a citrate buffer (pH 6.0). Section was blocked with 10% normal goat serum 30min at RT. Then primary antibody (1% BSA) was incubated at 4°C overnight. The primary is detected by a Anti-Human lgG, Fcy Fragment Specific labeled by HRP and visualized using 0.05% DAB.
-
IHC image of CSB-RA002005MA1HU diluted at 1:50 and staining in paraffin-embedded human testis tissue performed on a Leica BondTM system. After dewaxing and hydration, antigen retrieval was mediated by high pressure in a citrate buffer (pH 6.0). Section was blocked with 10% normal goat serum 30min at RT. Then primary antibody (1% BSA) was incubated at 4°C overnight. The primary is detected by a Anti-Human lgG, Fcy Fragment Specific labeled by HRP and visualized using 0.05% DAB.
-
-
其他:
產品詳情
-
Uniprot No.:
-
基因名:ARG1
-
別名:A I antibody; Al antibody; ARG 1 antibody; arg1 antibody; ARGI1_HUMAN antibody; Arginase 1 antibody; Arginase liver antibody; Arginase type I antibody; Arginase; liver antibody; Arginase-1 antibody; Arginase1 antibody; Liver type arginase antibody; Liver-type arginase antibody; Type I arginase antibody
-
反應種屬:Human
-
免疫原:Recombinant Human ARG1 protein
-
免疫原種屬:Homo sapiens (Human)
-
標記方式:Non-conjugated
-
克隆類型:Monoclonal
-
抗體亞型:hIgG1
-
純化方式:Affinity-chromatography
-
克隆號:6F1
-
濃度:It differs from different batches. Please contact us to confirm it.
-
保存緩沖液:Preservative: 0.03% Proclin 300
Constituents: 50% Glycerol, 0.01M PBS, PH 7.4 -
產品提供形式:Liquid
-
應用范圍:ELISA, IHC
-
推薦稀釋比:
Application Recommended Dilution IHC 1:50-1:200 -
Protocols:
-
儲存條件:Upon receipt, store at -20°C or -80°C. Avoid repeated freeze.
-
貨期:Basically, we can dispatch the products out in 1-3 working days after receiving your orders. Delivery time maybe differs from different purchasing way or location, please kindly consult your local distributors for specific delivery time.
-
用途:For Research Use Only. Not for use in diagnostic or therapeutic procedures.
相關產品
靶點詳情
-
功能:Key element of the urea cycle converting L-arginine to urea and L-ornithine, which is further metabolized into metabolites proline and polyamides that drive collagen synthesis and bioenergetic pathways critical for cell proliferation, respectively; the urea cycle takes place primarily in the liver and, to a lesser extent, in the kidneys.; Functions in L-arginine homeostasis in nonhepatic tissues characterized by the competition between nitric oxide synthase (NOS) and arginase for the available intracellular substrate arginine. Arginine metabolism is a critical regulator of innate and adaptive immune responses. Involved in an antimicrobial effector pathway in polymorphonuclear granulocytes (PMN). Upon PMN cell death is liberated from the phagolysosome and depletes arginine in the microenvironment leading to suppressed T cell and natural killer (NK) cell proliferation and cytokine secretion. In group 2 innate lymphoid cells (ILC2s) promotes acute type 2 inflammation in the lung and is involved in optimal ILC2 proliferation but not survival. In humans, the immunological role in the monocytic/macrophage/dendritic cell (DC) lineage is unsure.
-
基因功能參考文獻:
- study of the significance of heat activation and the role of metal ions in human arginase PMID: 30282613
- TGF-beta1 and arginase-1 may play important roles in determining long-term graft survival. PMID: 30074212
- These results showed that arginase controlled sFlt-1 elevation to some extent. PMID: 29548823
- ARG1 gene polymorphisms and their association in individuals with essential hypertension in Pakistan has been presented. PMID: 29756997
- A subset of well-differentiated hepatocellular carcinomas are arginase-1 negative. PMID: 28970136
- The data in this study suggest that arginase I inhibition potentially represents a novel therapeutic target for the prevention and/or treatment of bronchopulmonary dysplasia-associated pulmonary hypertension. PMID: 27895230
- this study shows that infiltrating macrophages expressing Arg1 are present in active allergic contact dermatitis lesions PMID: 28747341
- High arginase expression is associated with glioblastoma. PMID: 27006175
- Report the value of Arg-1 in distinguishing HepPar-1-positive prostatic carcinoma from hepatocellular carcinoma at metastatic sites or cases of liver metastasis from prostate carcinoma. PMID: 27184483
- AEG-1 is positively activated in the tumorigenesis and deterioration of NSCLC. PMID: 28152520
- Arginase-1 expression is common (62.5%) in hepatoid adenocarcinoma and hence it is not useful in distinguishing hepatocellular carcinoma from hepatoid adenocarcinoma. PMID: 27137985
- Arginase 1 was highly expressed by tumor-associated Gr1+ microglia and macrophages. PMID: 27936099
- The authors report here that Candida albicans blocks nitric oxide production in human-monocyte-derived macrophages by induction of host arginase activity. PMID: 28119468
- Evidence for a negative association of arginase I with job strain and positive association with job control and social support in females. PMID: 28403218
- Two argininemia patients were initially diagnosed by tandem mass spectrometry in newborn screening. Mutation analysis of the ARG1 gene was performed by direct sequencing.Two missense mutations, p.D100N and p.R71T, in Patient-1 were predicted to lower the stability of arginase Iota by analysis of 3D crystal structure, while two nonsense mutations, p.G12X and p.E42X, in Patient-2 were predicted to lead to truncated protein. PMID: 28089752
- The results of this study suggested a novel relationship exists between ARG1, neutrophil-lymphocyte ratio , and stroke severity which may help guide future mechanistic studies of post-stroke immune suppression. PMID: 26515089
- This study provides a molecular mechanism of the pathogenesis of systemic lupus erythematosus by demonstrating an Arg-1-dependent effect of myeloid-derived suppressor cells in the development of TH17 cell-associated autoimmunity. PMID: 27009269
- ARG1 rs2781659 AA and rs2781667 TT genotypes were associated with lower IIEF scores (increased severity) in clinical erectile dysfunction (ED), whereas ARG1 GTCC haplotype is associated with higher IIEF scores in clinical ED, thus suggesting a genetic contribution of ARG1 variations to ED PMID: 26537638
- These results showed that alterations in the expression levels of Arg I and iNOS in the peripheral T cells and peripheral nodes of HIV infected patients are associated with disease progression in these patients. PMID: 26647762
- Increased ARG1 expression in macrophages after a single radiotherapy dose is an independent prognostic factor of skin toxicities. PMID: 26061397
- Arginase inhibition arrests human pulmonary artery smooth muscle cells in the G1/G0-phase under hypoxic conditions. PMID: 26126810
- Arginase from neutrophils can modulate nitric oxide production from activated macrophages which may affect the course of infection by intracellular bacteria. PMID: 26119192
- Overexpression and elevated activity of arginase I are involved in tobacco-induced pulmonary endothelial dysfunction. PMID: 25889611
- This method not only solved the problem of obtaining a large amount of arginase, but also provided a promising alternative for the future industrial production of L-Orn. PMID: 26227111
- the combination of high levels of CD14, FOXP3, and ARG1 mRNAs identified a small group of patients with excellent event-free and overall survival. PMID: 26161395
- Overexpression of Arg1 in the CNS of transgenic mice significantly reduced tau pathology. PMID: 26538654
- data indicate that helminth coinfection induces arginase-1-expressing type 2 granulomas, thereby increasing inflammation and TB disease severity. PMID: 26571397
- The data exclude a prognostic role of IL-10 and ARG-1 in metastatic neuroblastoma. PMID: 25961062
- Arginase activity increases in peripheral blood of patients with intestinal schistosomiasis. PMID: 25786588
- Data indicate that arginase-1 showed positivity in 2 ampullary region carcinomas and diffuse positivity in 1 duodenal adenocarcinoma. PMID: 26030248
- Arg1 induced accumulation of autophagosomes in MDA-MB-231 cells. PMID: 25501824
- Arg1 and PD-L1 are dynamically modulated upon neutrophil migration into human airways, and, Arg1, but not PD-L1, contributes to early neutrophil-driven T cell suppression in cystic fibrosis, likely hampering resolution of infection and inflammation. PMID: 25926674
- These results suggest that ARG1 and GABA influence both neural development and neuroblastoma and that benzodiazepines in clinical use may have potential applications for neuroblastoma therapy. PMID: 25437558
- Arg1 expression is decreased, and Arg2 expression is increased in the newborn congenital obstructive nephropathy and in the mouse model. PMID: 25205225
- rs2781666 may be associated with protection against pulmonary hypertension in preterm neonates with bronchopulmonary dysplasia PMID: 24919409
- The plasma levels of arginase I was higher in patients with DCL. PMID: 25124926
- Novel variants in the ARG1 locus associated with CRP levels in cardiovascular disease in a Korean population. [Meta-analysis] PMID: 24763700
- Arginase I levels are decreased in the plasma of pediatric patients with atopic dermatitis. PMID: 25027824
- Arginase activity was higher in cord blood of gestational diabetes mellitus mothers as opposed to the control group. PMID: 24376824
- Our results suggest that serum ARG and CRP together can efficiently diagnose Head and neck squamous cell carcinoma. PMID: 24715304
- Serum arginase I might regulate serum L-arginine and 3-nitrotyrosine via L-arginine. PMID: 24060156
- The independent associations of arginase I with urinary 8-OHdG and serum insulin may reflect its involvement in oxidative stress and diabetes mellitus. PMID: 24005081
- Arginase-1 mRNA expression correlates with myeloid-derived suppressor cell levels in peripheral blood of NSCLC patients. PMID: 23850196
- Both arginase-1 and HepPar-1 are effective markers of hepatocellular differentiation PMID: 24281232
- This study demonistrated that Five novel mutations in ARG1 gene in Chinese patients of argininemia. PMID: 23859858
- Glypican 3 and arginase-1 are the most reliable markers for identifying scirrhous hepatocellular carcinoma. PMID: 23348905
- Enzymes that are directly involved in the formation of urea are expressed in ocular tissues. PMID: 23740519
- Results show that the positively charged state of arginine is stable in the active site of arginase I, with that stabilization facilitated by the presence of hydroxide. PMID: 23327293
- The tumor suppressive function of arginase-I in both infiltrating and circulating myeloid-derived suppressor cells is a downstream target of activated STAT3. PMID: 23454751
- results suggest that Arg-1 may play a tumor suppressive role in HCC and could be a new, promising prognostic biomarker for HCC patients PMID: 23505904
顯示更多
收起更多
-
相關疾病:Argininemia (ARGIN)
-
亞細胞定位:Cytoplasm. Cytoplasmic granule.
-
蛋白家族:Arginase family
-
組織特異性:Within the immune system initially reported to be selectively expressed in granulocytes (polymorphonuclear leukocytes [PMNs]). Also detected in macrophages mycobacterial granulomas. Expressed in group2 innate lymphoid cells (ILC2s) during lung disease.
-
數據庫鏈接:
Most popular with customers
-
-
YWHAB Recombinant Monoclonal Antibody
Applications: ELISA, WB, IHC, IF, FC
Species Reactivity: Human, Mouse, Rat
-
Phospho-YAP1 (S127) Recombinant Monoclonal Antibody
Applications: ELISA, WB, IHC
Species Reactivity: Human
-
-
-
-
-